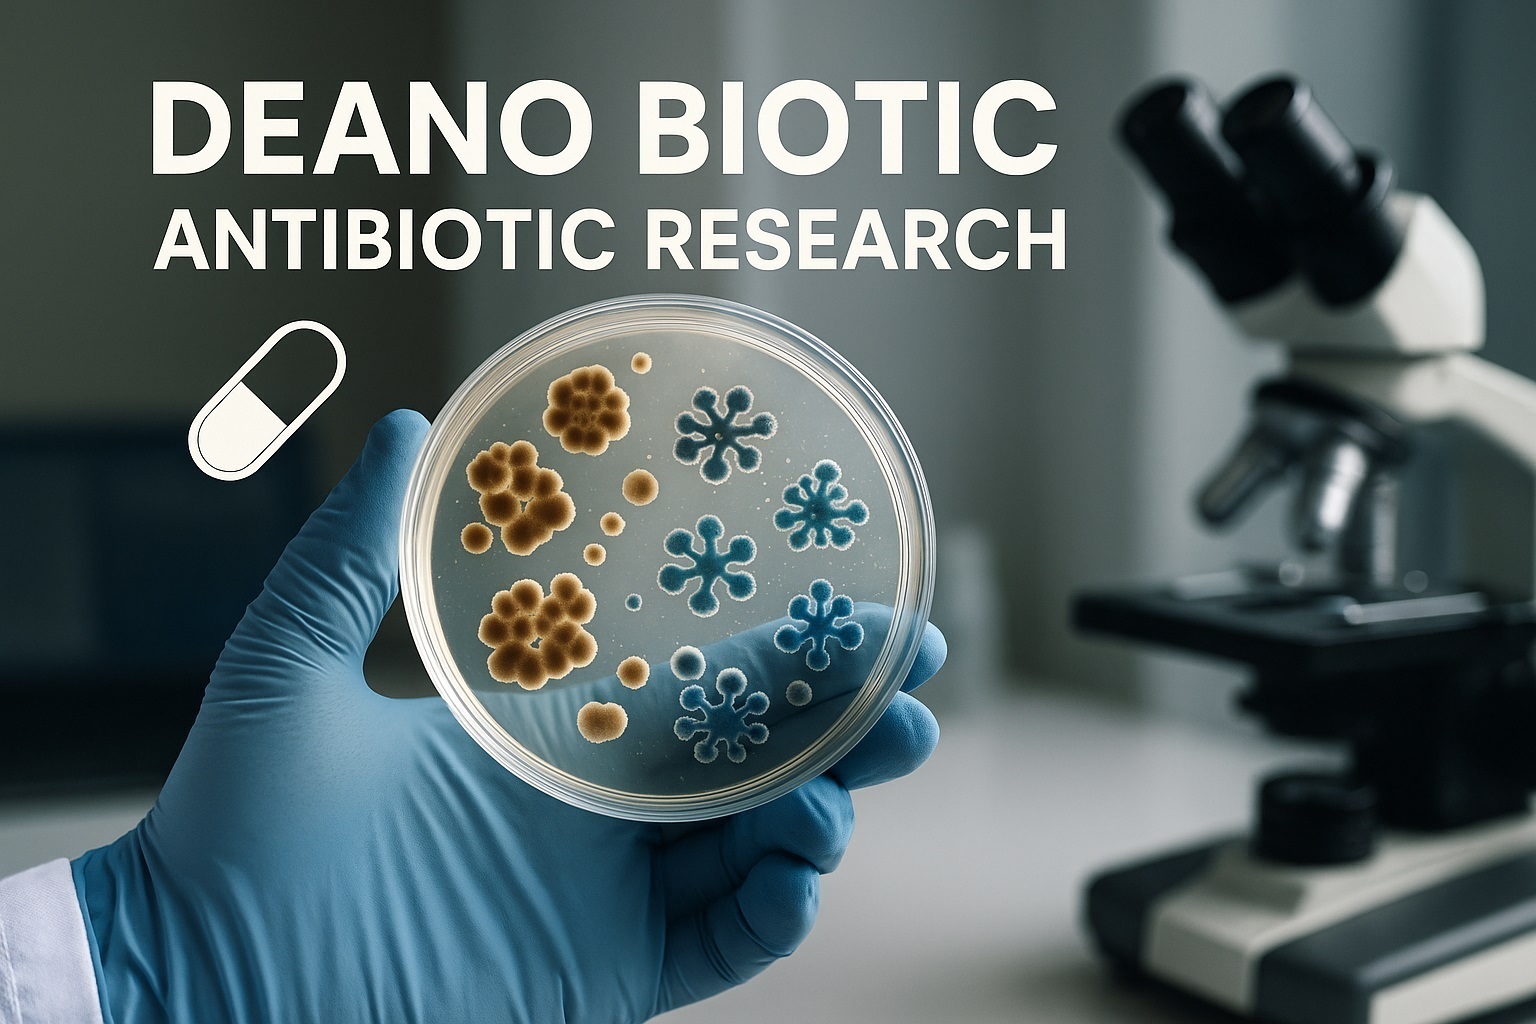
Research Lab

Pioneering Pharmaceutical Research
Driving innovation through cutting-edge scientific discovery and translational research to develop next-generation therapeutics.
Our Research Recent Publications
Driving innovation through cutting-edge scientific discovery and translational research to develop next-generation therapeutics.
Our Research Recent Publications
Innovating at the intersection of science and medicine
Developing targeted therapies based on genetic profiling and personalized medicine approaches.
Learn MoreAdvancing treatments for neurological disorders including Alzheimer's and Parkinson's disease.
Learn MoreDeveloping novel antibiotics to combat drug-resistant bacterial strains.
Learn MoreInnovative approaches to treating heart disease and related conditions.
Learn MoreDeveloping advanced treatments for asthma, COPD, and pulmonary diseases.
Learn MoreLeveraging artificial intelligence to accelerate pharmaceutical innovation.
Learn MoreRecent breakthroughs and ongoing projects
Our team has developed a novel delivery system for CRISPR-based gene editing that shows 90% efficiency in preclinical trials.
Read StudyOur Alzheimer's treatment candidate shows significant cognitive improvement in 65% of patients during Phase 3 trials.
View ResultsOur AI platform identified 3 promising new drug candidates for rare diseases in just 6 months of development.
Learn MoreWorld-class scientists driving pharmaceutical innovation

Chief Scientific Officer

Director of Genomics

Head of Neuroscience

AI Research Lead
Peer-reviewed research from our team
Nature Biotechnology, 2023
Our team developed a novel lipid nanoparticle delivery system that improves CRISPR efficiency by 300%...
Read AbstractScience Advances, 2023
We demonstrate how our AI platform can reduce drug discovery timelines by 40% while maintaining accuracy...
Read AbstractCell, 2022
Our research identifies a new class of antibiotics effective against drug-resistant Gram-negative bacteria...
Read AbstractNew England Journal of Medicine, 2022
Clinical trial results showing 45% better outcomes using genomic profiling to guide treatment decisions...
Read Abstract